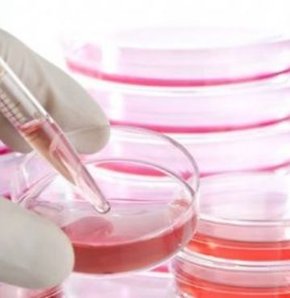

Kök hücreden kornea üretildi
ABD'deki Massachusetts Göz ve Kulak Enstitüsü'nden bilim insanları, kök hücreden kornea üretmeyi başardı. Çalışmaların, kornea tedavisinde bir dönüm noktası olacağı kaydedildi.
Gelişmenin kimyasal saldırılarda yaralanan ya da farklı göz hastalıklarıyla mücadele eden kişiler için umut verici olduğu belirtildi. Çalışmayı yürüten bilim insanları limbal kök hücre gibi davranan ABCB5 adlı bir molekülü de kullanarak, kornea tabakasının görüş kabiliyetini yenilemesini sağlayabiliyor.
Kök hücrede 'Quantum' müjdesi!
Türkiye'de biyoreaktörle ilk kök hücre, Adana'da üretildi. 'Quantum' adı verilen cihazla 10 günde 160 bin hücreden tam 200 milyon hücre üretildi.emik iliği yetersizliği ve bağışıklık sistemini ilgilendiren hastalıklarda 'kök hücre' müjdesi!
Türkiye'de biyoreaktörle 'ilk kök hücre' üretildi. 'Quantum' adı verilen cihazla 10 gün süren çalışmaların sonucunda 160 bin hücreden tam 200 milyon hücre üretildi. Bunun da Türkiye'de bir ilk olduğu vurgulandı.
'QUANTUM' MUCİZESİ
ABD, Almanya, Belçika, Danimarka ve Tayland'dan sonra Türkiye'de de biyoreaktörle 'kök hücre' üretildi. Başkent Üniversitesi Adana Araştırma ve Uygulama Merkezi'nde dünyada sadece 9 merkezde bulunan ve 'Quantum' adı verilen cihazla kemik iliğinden alınan hücrelerden biyoreaktörler aracılığı ile 'kök hücre' üretildi. Erişkin Kemik İliği Merkezi Hücre İşleme Ünitesi'ndeki çalışmalar 10 gün sürdü.
200 MİLYON KÖK HÜCRE
Söz konusu çalışmalarla birlikte kemik iliğinden alınan 160 bin hücreden toplam 200 milyon hücre ürettiklerini açıklayan Hücre İşleme Ünitesi ekibinin Direktörü Doç. Dr. İlknur Kozanoğlu, "Kısa zamanda kök hücrelerin yeterli sayıda üretilmesi çok önemli, çünkü yaşam mücadelesi veren hastaların uzun süre beklemesi mümkün olamıyor" dedi. Kozanoğlu, klasik yöntemlerle kültür ortamında üretilen hücrelerin mikrobik bulaşmalara açık olduğunu belirtti.
ÖNEMLİ İLERLEMELER
Bunun önlenebilmesi için çok pahalı bir alt yapı ve personel ile GMP uygulamalarının gerektiğine işaret eden Doç. Dr. Kozanoğlu, 'Quantum' cihazı ile aynı kapalı koşulların sağlanabildiğini anlattı. Kozanoğlu, üretilen kök hücre ürününün kalite kontrol çalışmalarının tamamlanması ile kişiye özgü kök hücre üretiminde önemli ilerlemeler sağlanacağı müjdesini de verdi.
KEMİK İLİĞİNDE MÜJDE
Kozanoğlu "Bu çalışmaların tümünün kanun ve yönetmelikler ve uluslararası standartlara uygun olması gerekiyor" ifadesini kullandı. Son yıllarda kök hücrelerin, bilim insanlarının da ilgisini çektiğini hatırlatan Kozanoğlu, bu hücrelerin de kemik iliği yetersizliği ve bağışıklık sistemini ilgilendiren hastalıkların tedavisi için klinik uygulamalarda kullanıldığını söyledi. Kozanoğlu, açıklamasını da şöyle sürdürdü:
TÜRKİYE'DE BİR İLK
"Aktık hastanemizde dünyada sadece 9 merkezde bulunan cihazla biyolojik ortam birebir sağlanabiliyor. Bu cihazla, hızlı ve standart üretim sağlıyorlar. Bu teknoloji çok çok yeni ve bu bütün dünyada şuanda 9 merkezde kurulmuş durumda. Eş zamanlı olarak bizde kuruldu. Çoğunlukla ABD'de, Almanya'da, Belçika'da, Danimarka'da ve Tayland'da bulunan bu cihazla kök hücre üretimi Türkiye'de ilk kez hastanemizde başladı."